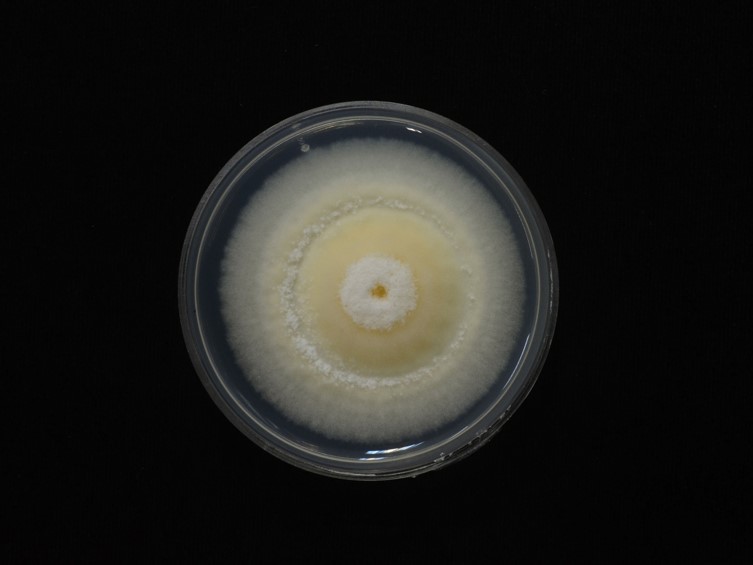

Holotype:
THAILAND, Nakhon Ratchasima Province, Khao Yai National Park, 10 Jul. 2007, T. Laessøe, J.J. Luangsa-ard, R. Ridkaew, B. Thongnuch, P. Srikitikulchai, holotype BBH 23231, ex-type living culture BCC 26300.
Habitat:
Leaf litters, buried in the soil.
Host:
Adult beetle, Lepidoptera larva, mole crickets.
Description:
 Stroma one or two arising on Lepidoptera larvae, adult beetle (Coleoptera), and mole cricket (Orthoptera) protruding from the ground, solitary, clavate, cylindrical with rounded apices, 30-55 mm long, white with slightly rhizoid mycelia covering the host, orange white to light orange, pinkish white to pale red. Fertile head showing on the upper part of stromata, clavate, cylindrical with rounded apices, light orange, pale red, 15-22 × 2-3 mm.
Stroma one or two arising on Lepidoptera larvae, adult beetle (Coleoptera), and mole cricket (Orthoptera) protruding from the ground, solitary, clavate, cylindrical with rounded apices, 30-55 mm long, white with slightly rhizoid mycelia covering the host, orange white to light orange, pinkish white to pale red. Fertile head showing on the upper part of stromata, clavate, cylindrical with rounded apices, light orange, pale red, 15-22 × 2-3 mm.  Perithecia semi-immersed and crowded at the apex of stromata, obclavate to ovoid, 200-400 × 80-200 μm.
Perithecia semi-immersed and crowded at the apex of stromata, obclavate to ovoid, 200-400 × 80-200 μm.  Asci hyaline, cylindrical, capitate, 182-313 × 4-5 μm. Asci-caps hyaline, rounded, 2-3 × 3-4 μm.
Asci hyaline, cylindrical, capitate, 182-313 × 4-5 μm. Asci-caps hyaline, rounded, 2-3 × 3-4 μm.  Ascospores hyaline, filiform, multi-septate and breakdown into 64 part-spores, 250-388 × 1-1.5 μm. Part-spores hyaline, cylindrical, 4-12 × 1-1.5 μm. Vegetative hyphae hyaline, septate, branched, curved, smooth-walled. Phialides hyaline, solitary, smooth-walled, ampulliform, subglobose, ovoid, obpyriform, 3-7 × 1-2 μm. Conidia hyaline, walls smooth, globose to subglobose, broadly ellipsoid, 1-3 × 1-3 μm.
Ascospores hyaline, filiform, multi-septate and breakdown into 64 part-spores, 250-388 × 1-1.5 μm. Part-spores hyaline, cylindrical, 4-12 × 1-1.5 μm. Vegetative hyphae hyaline, septate, branched, curved, smooth-walled. Phialides hyaline, solitary, smooth-walled, ampulliform, subglobose, ovoid, obpyriform, 3-7 × 1-2 μm. Conidia hyaline, walls smooth, globose to subglobose, broadly ellipsoid, 1-3 × 1-3 μm.
Culture characteristics:
Colony on PDA dense, velutinous, floccose, closely appressed and slightly convex to the agar surface, orange white in the middle, white in the middle and margin, sporulation starts at 15 d after inoculation, 25−30 mm diam in 10 d, 50−53 diam in 20 d.
Colony on PDA dense, velutinous, floccose, closely appressed and slightly convex to the agar surface, orange white in the middle, white in the middle and margin, sporulation starts at 15 d after inoculation, 25−30 mm diam in 10 d, 50−53 diam in 20 d.
Reference:
Ariyawansa HA, Hyde KD, Jayasiri SC, et al. (2015). Fungal diversity notes 111–252—taxonomic and phylogenetic contributions to fungal taxa. Fungal Diversity 75: 27–274.
DOI: https://doi.org/10.1007/s13225-015-0346-5Khonsanit A, Luangsa-ard JJ, Thanakitpipattana D, et al. (2020). Cryptic diversity of the genus Beauveria with a new species from Thailand. Mycological Progress 19: 291–315.
DOI: https://doi.org/10.1007/s11557-020-01557-9Species |
Strain |
Compound |
Pubchem CID |
Biological activity |
Reference |
|---|
|
Strain |
Bloc | ITS | RPB1 | RPB2 | TEF1 |
|---|---|---|---|---|---|
| BCC 19481 | - | FJ84321 | - | - | FJ584323 |
| BCC 26300 | - | FJ459787 | MK632184 | MK632152 | FJ459795 |
| BCC 75786 | - | MN104625 | MN401549 | - | MN401451 |
| BCC 75788 | MN401505 | MN401623 | MN401547 | MN401603 | MN401449 |
| BCC 76572 | - | MN401624 | MN401548 | - | MN401450 |
| BCC 81472 | MK401506 | MK632053 | MK632178 | MK632151 | MK632068 |